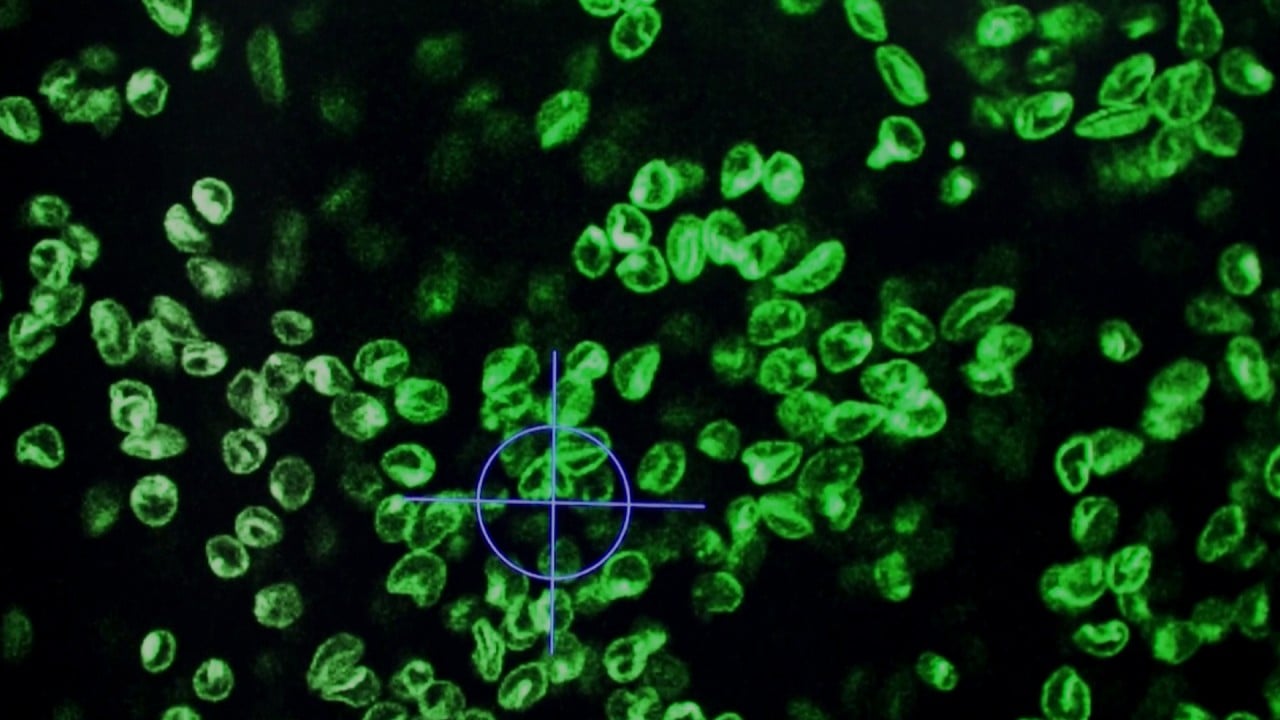

Изследователите от Обединеното кралство заявиха в сряда, че са забавили прогресията на фаталното невронно състояние на болестта на Хънтингтън за първи път с новаторска нова генна терапия.
Някои пациенти, които участваха в клинични изпитвания в ранен етап в University College London (UCL), видяха скоростта, с която състоянието им се развива намалена със 75 % след три години, според Uniqure, компания за генна терапия със седалище в Холандия и САЩ.
Проучването тества нова генна терапия, AMT-130, която се доставя чрез инжекция директно в мозъка.
Изследователите заявиха, че AMT-130 работи, като постоянно въвежда нова функционална ДНК в клетките на пациента.
„Този резултат променя всичко“, заяви водещият изследовател Ед Уайлд от Центъра за болести на Хънтингтън на UCL. „Въз основа на тези резултати изглежда вероятно AMT-130 ще бъде първото лицензирано лечение за забавяне на болестта на Хънтингтън, което е наистина променящо света неща“, добави той.

02:04
Генна терапия, която би могла да забави стареенето на хората, открити от китайските изследователи в проучвания върху мишки
Генна терапия, която би могла да забави стареенето на хората, открити от китайските изследователи в проучвания върху мишки
Около 29 пациенти са участвали в проучването с 12 -те, на които е дадена най -висока доза, изпитваща най -голямо забавяне на болестта.
Source link
Like this:
Like Loading…
Нашия източник е Българо-Китайска Търговско-промишлена палaта